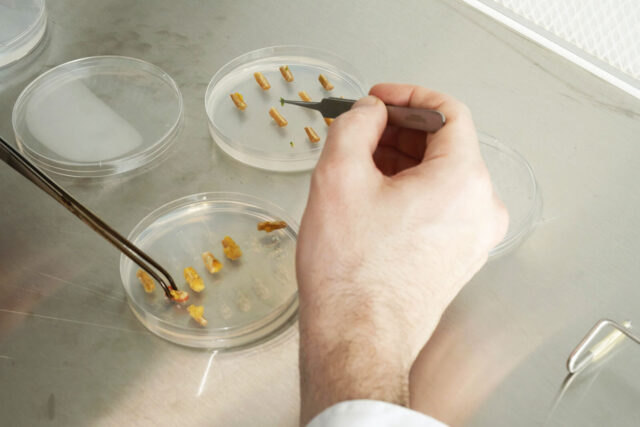

Wageningen
Neue Räume für die Zellbiologie
KWS Gemüse hat am Hauptstandort der Business Unit in Wageningen eine neue Forschungseinrichtung eröffnet. Der Schwerpunkt liegt auf einer Methode, mit der die Geschwindigkeit und die Effizienz der Züchtungsprozesse erheblich gesteigert werden können.

Die Inbetriebnahme der neuen Laboreinrichtungen in Wageningen ist ein wichtiger Schritt in Hinblick auf Geschwindigkeit und Qualität bei der Entwicklung neuer Sorten“, sagt Paul Degreef, Leiter der Business Unit Gemüse. „Mit innovativen Züchtungsansätzen wie der Doppelhaploid-Methode (DH), auf die wir uns hier am Standort konzentrieren, können wir schneller auf die Bedürfnisse der Züchterinnen und Züchter sowie der Konsumentinnen und Konsumenten reagieren. Dazu gehören Krankheitsresistenzen und Ertragsstabilität für die Erzeuger sowie Qualität, Geschmack und Aussehen der Früchte. Unsere Forschungseinrichtungen in Wageningen werden allen unseren Züchtungsteams weltweit zugutekommen.“

David Downey, Leiter der Zellbiologie in Wageningen, erklärt: „Homozygote Elternlinien zu erzeugen ist in der Pflanzenzüchtung unerlässlich und gleichzeitig eine Herausforderung. Mit der Doppelhaploid-Methode können wir reinerbige Linien in einer einzigen Generation erzeugen. Wir sparen damit beachtlich viel Zeit beim Entwickeln von Elternlinien.“ Bei herkömmlichen Methoden werden homozygote Linien durch wiederholte Selbstbestäubung erzeugt. Das dauert allerdings sieben bis acht Generationen, und selbst dann sind die erzeugten Pflanzen nicht zu hundert Prozent homozygot. In diesem Punkt ist die DH-Methode überlegen.
Züchtung beschleunigen
Das erste Resultat der Einrichtungen sind spezifische Züchtungslinien für Gurken und Paprika, die den Züchtungsstationen in Spanien, Italien, Mexiko und der Türkei bereitgestellt werden. „Unsere neuen Forschungseinrichtungen in Wageningen werden uns dabei helfen, die Züchtung zu beschleunigen, damit wir unseren Kunden in kürzerer Zeit hochwertige Sorten anbieten können“, sagt Pablo Fernández-Miranda, Paprikazüchter in Almeria, Spanien.
Das Zellbiologieteam in Wageningen und die Forschungsgruppe in Einbeck sind gut miteinander vernetzt und haben die DH-Protokolle gemeinsam entwickelt. Diese Zusammenarbeit ermöglicht es, mit der Produktion von DH-Linien für Paprika und Gurken in Wageningen ab Juli zu beginnen. Das ist sehr schnell, wenn man bedenkt, dass diese beiden Kulturen erst seit 2019 zum Portfolio von KWS gehören. Auch wenn der Schwerpunkt der DH-Gemüseprotokolle zu Beginn auf Gurke und Paprika liegt, sollen in Zukunft weitere Gemüsearten hinzukommen.
„Die Protokollentwicklung für Gurken- und Paprika-DH-Linien war eine unglaublich spannende und faszinierende neue Herausforderung für uns“, sagt Clemens Springmann, Forschungsleiter Zellbiologie. „Wir haben in kurzer Zeit viel gelernt und uns mit unseren Kolleginnen und Kollegen aus der Gemüsezüchtung, der Zellbiologie und der Molekularzüchtung ausgetauscht.“

Zentrale Drehscheibe der Business Unit Gemüse
Die Business Unit Gemüse hat ihren Sitz im Gebäudekomplex Plus Ultra II von Kadans Science Partner auf dem Campus des Universitäts- und Forschungszentrums Wageningen (Wageningen University & Research, kurz: WUR). Sie ist die zentrale Drehscheibe, von der aus die Aktivitäten der BU Gemüse gesteuert werden. Zurzeit sind 23 Mitarbeiterinnen und Mitarbeiter an diesem Standort tätig. Die neuen Forschungseinrichtungen haben eine Fläche von fast 450 Quadratmetern, darunter Laborräume, Regalflächen für Gewebekulturen und drei Klimakammern. |
Bei Fragen wenden Sie sich an:
© KWS SAAT SE & Co. KGaA 2026
















